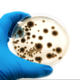
Screen shot 2018 03 17 at 12.10.21 pm

-
1st to observe a “microscopic mushroom” (mold) with a simple “microscope”
-
Made better lenses, observed bacteria, protozoa, algae, etc. Wrote the Royal Society of London
-
-
Introduces vaccination for smallpox
-
Proposed that microscopic organisms are causative agents in several diseases.
-
Refutes spontaneous generation.
-
Microbes cause wound infections; antiseptic surgery
-
Developed pure culture and other lab techniques
-
Describes the Gram Stain
-
Discover structure of DNA.
-
Classifies all organisms into three domains
Plan projects on a visual timeline
Map milestones, phases, deadlines, and key events in one place so the sequence is easier to see and share. Timetoast is a timeline maker for work, school, research, and stories.